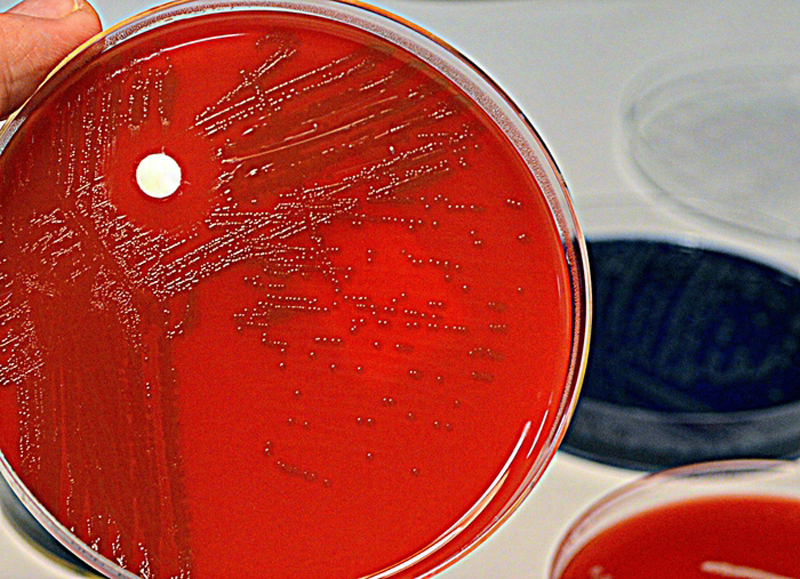

Sviluppato test rapido ed economico per diagnosticare la setticemia
Dall'analisi di una sola goccia di sangue diventa possibile diagnosticare la setticemia, la pericolosa reazione immunitaria dovuta a una grave infezione estesa a tutto l'organismo. Descritto sulla rivista Nature Biomedical Engineering, il test è economico e rapido, in quanto dà risposte in poche ore, ed è stato sviluppato da Daniel Irimia, del Massachusetts General Hospital di Boston.
Il risultato arriva da uno studio preliminare condotto su quarantadue individui (con sepsi e non); il test si basa su un apparecchietto che contiene un labirinto di microscopici canali sui quali viene colata la goccia di sangue. Un software analizza il modo in cui si muovono sul labirinto le cellule immunitarie chiamate neutrofili, implicate nella setticemia e in pochissime ore riesce a distinguere se il sangue esaminato è di un paziente con sepsi oppure no.
Come detto, l'accuratezza del prototipo è stata dimostrata su un primo campione di quarantadue individui, dimostrando una specificità e una sensibilità del 95%. Se la sua efficacia sarà convalidata su un campione più ampio di soggetti, il test è potenzialmente in grado di rivoluzionare la diagnosi di setticemia. Una diagnosi che oggi viene fatta in modo erroneo nel 30% dei casi, portando o a uso ingiustificato di antibiotici o al contrario a rischio di morte del paziente.
(ANSA)
clicca e scopri come sostenerci







